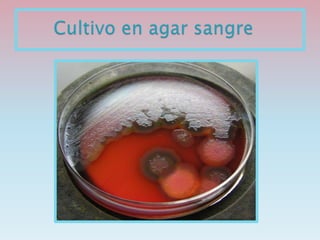
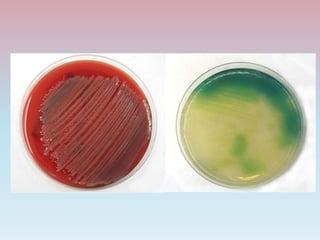

Pseudomonas aeruginosa es una bacteria Gram-negativa, aerobia obligada, móvil, que produce pigmentos azules y verdes. Se encuentra ampliamente distribuida en la naturaleza y puede causar infecciones nosocomiales. Es resistente a múltiples antibióticos pero tratable con aminoglicósidos, quinolonas y cefalosporinas de amplio espectro.